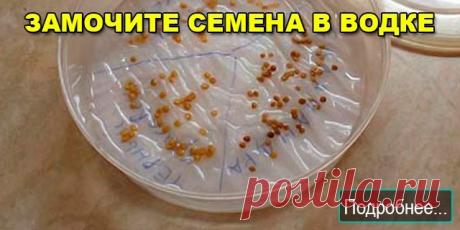
ЗАМОЧИТЕ СЕМЕНА В ВОДКЕ - ПОЛЕЗНЫЕ СОВЕТЫ

39 ДАЧА - ВСЕВОЗМОЖНЫЕ ПОЛЕЗНЫЕ СОВЕТЫ ДЛЯ САДА,ОГОРОДА
полезные советы
Развернуть
dzen.ru
10 замечательных идей как хранить обувь в саду и на даче Обычно после огородных работ с землей, травой, опавшими листьями или снегом мы заходим домой, ставим обувь прямо на пол или на коврик у входной двери, а через несколько минут наблюдаем огромную, грязную лужу. Кроме того, когда хочется надеть обувь снова, мы понимаем, что внутри она не просохла как следует, поэтому ногам очень неприятно.
Для того чтобы дачная или садовая обувь всегда служила вам ве
ogorod.ru
Чего не нужно делать в саду весной – 10 главных ошибок начинающих садоводов Наступление календарной весны пробуждает в садоводах неистовое желание немедленно бежать на участок и что-то делать. Быстрей, быстрей, весенний день год кормит… Остановитесь на миг и задумайтесь – возможно, именно сейчас вы вредите своим посадкам.
ogorod.ru
Чего не нужно делать в саду весной – 10 главных ошибок начинающих садоводов Наступление календарной весны пробуждает в садоводах неистовое желание немедленно бежать на участок и что-то делать. Быстрей, быстрей, весенний день год кормит… Остановитесь на миг и задумайтесь – возможно, именно сейчас вы вредите своим посадкам.
ok.ru
Маленькие секретики садоводу - огороднику. Добавь себе на стену, чтобы не забыть!
1. Йод для капусты. В ведро воды добавить 40 капель йода. Когда начнет формироваться кочан, поливать капусту под растение по 1 литру.
2. Ускорение пророста. Чтобы семена быстрее проросли их замачивают в растворе перекиси водорода (4%) на 12 часов (капуста), а семена помидоров и свеклы - на 24 часа. Для обеззараживания семян (вместо марганцовки) их обрабатывают 10% перекисью водорода 20 мину...
dzen.ru
Вы зря думаете, что триммером можно только косить траву. Читайте и смотрите, на что он способен Много раз наблюдал как косят газоны и траву на дачных участках, и мне захотелось узнать, на что еще годен этот агрегат, ведь наверное не только для сезонного использования.
Я подумал, что такой аппарат наверняка на многое способен, и не только для летних работ.
Решил посмотреть в интернете и то, что я нашел, меня просто поразило.
Оказывается, с помощью триммера практически все работы по саду и ого
ogorod.ru
50 нестандартных идей, как можно хранить вещи на даче У владельцев больших дачных домов и хозяев небольших построек есть кое-что общее: они хотят, чтобы вещи и инструменты хранились в порядке и были всегда под рукой. Поэтому сегодня мы расскажем, как этого добиться с помощью необычных способов.
dzen.ru
7 полезных применений газет в огороде За зиму у меня дома накапливается большая стопка газет. Я их не выбрасываю, а привожу весной на дачу и применяю их там с пользой для огорода. Речь идет не о любой печатной продукции, а именно о газетах, глянцевые журналы нам не подойдут.
Расскажу для чего я в дальнейшем их использую.
1. Для розжига
Это самый распространенный вариант. Бумага отлично горит, поэтому может быть использована для розжиг
ogorod.ru
10 садовых изобретений, с которыми проще работать на участке Работы на даче – вовсе не каторга и не отработка повинности. Они могут стать приятным времяпрепровождением, если вы оснащены по последнему слову технической мысли. Мы отобрали для вас несколько заслуживающих внимания изобретений.
dzen.ru
Используем старые газеты и картон с пользой для огорода У каждого человека дома рано или поздно скапливается большое количество ненужной бумаги. Газеты, рисунки, тетради, картонные коробки - все это выбрасывается или сдается в макулатуру. И очень зря. Ведь бумага может быть очень полезная для огорода и садоводческого быта.
В этой статье я хочу рассказать о том, как использую старую бумагу у себя в огороде.
1. Бумажные горшочки для рассады
В самом начал
ymsovet.ru
Она воткнула в землю вилки по всему саду. Причина тому была просто гениальной! Не каждый опытный садовод знает об этом. Настоящие садоводы знают, как сложно избавиться от нежелательных гостей на своих грядках и клумбах. Поэтому и придумывают различные, порой даже поразительные и уникальны способы, чтобы защитить свои насаждения от различных грызунов и вредителей. Сегодня вы
dzen.ru
Используем старые газеты и картон с пользой для огорода У каждого человека дома рано или поздно скапливается большое количество ненужной бумаги. Газеты, рисунки, тетради, картонные коробки - все это выбрасывается или сдается в макулатуру. И очень зря. Ведь бумага может быть очень полезная для огорода и садоводческого быта.
В этой статье я хочу рассказать о том, как использую старую бумагу у себя в огороде.
1. Бумажные горшочки для рассады
В самом начал
ogorod.ru
Подводим итоги: 7 дачных хитростей, которым я научился в 2018 году Каждый дачник в процессе освоения своего участка обязательно постоянно чему-то учится. Кто-то осваивает новые технологии выращивания растений, кто-то обучается построению теплицы, кто-то открывает для себя теплые грядки, кто-то находит новые удачные сорта растений или оптимально действующие удобрения…